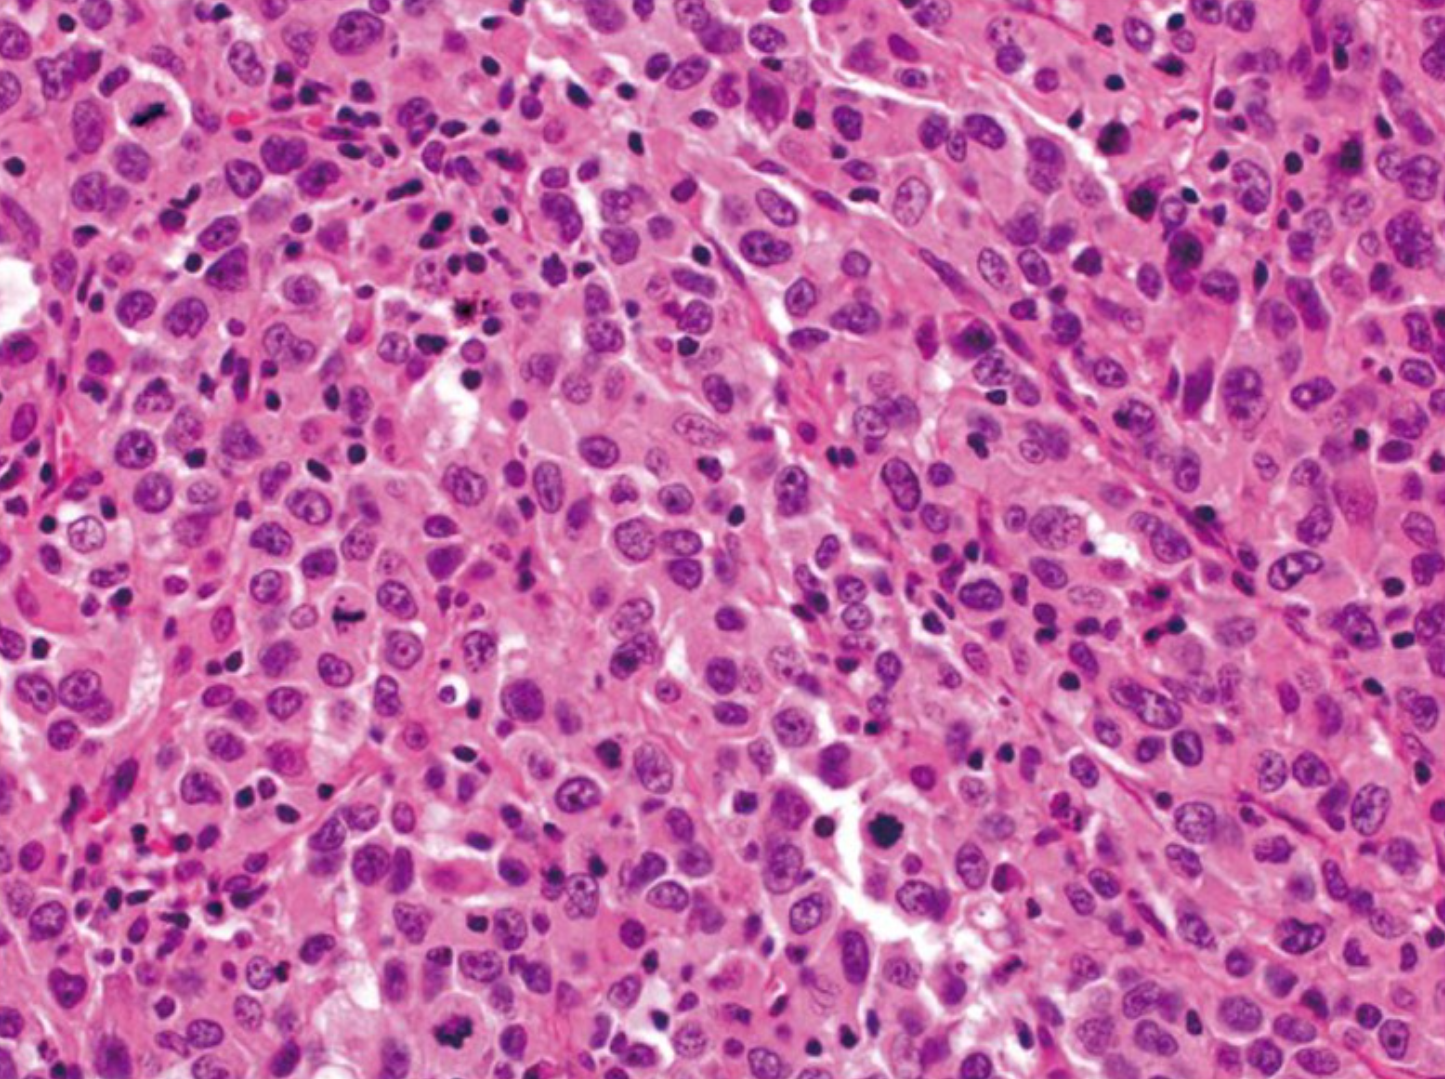
若本图无法展示,请更换浏览器查看

大肠癌(包括结肠癌和直肠癌)(colorectal cancer,CRC)是消化道常见的恶性肿瘤,有时也成为结直肠癌, 其发病率和死亡率在全球范围内呈上升趋势。近年来,随着生活方式西化、 肥胖率攀升及人口老龄化加剧,大肠癌的发病呈现年轻化趋势,早期症状隐匿, 易被误诊为痔疮或肠炎,导致多数患者确诊时已进展至中晚期。
世界卫生组织国际癌症研究机构(IARC)发布的 2020 年全球最新癌症负担数据显示, 结肠癌是全球第五大常见癌症,2020 年全球新发病例数达 114.85 万,占所有癌症新发病例的 6.0%。 直肠癌是全球第八大常见癌症,2020 年全球新发病例数达 73.22 万,占所有癌症新发病例的 3.8%。 2020 年全球因结肠癌死亡人数约 57.69 万,占癌症死亡总数的 5.8%。 同年全球因直肠癌死亡人数约 33.9 万,占癌症死亡总数的 3.4% [1]。

图1.2020年及2040年预测结直肠癌发病率最高的10个国家 [2]。
近年来,中国大肠癌的发病率和死亡率均呈上升趋势。在我国恶性肿瘤发病中,大肠癌已位居第二。 2022 年中国大肠癌新发病例数约 51.71 万,其中男性新发病例数约 30.77 万,女性新发病例数约 20.94 万。 2020 年中国大肠癌死亡病例数约 24 万,其中男性病例数约 14.26 万,女性病例数约 9.74 万 [3]。
结直肠癌筛查可使结直肠癌的发病率和死亡率下降。 我国在天津、上海、浙江和广州等地由政府组织的全人群结直肠癌筛查结果也证明了结直肠癌筛查的效益。 目前,推荐的结直肠癌筛查方案主要是危险度评估和粪便潜血,若为阳性,再进行结肠镜检查。 近年来类便DNA检测可以进一步提高结直肠癌粪便初筛的效益口。 国外的经验还表明,在医疗资源较为发达的地区,直接应用3~5年1次的结肠镜检查,也可以取得较好的筛查效果。
大肠癌,又称为结直肠癌(Colorectal Carcinoma),是指发生在结肠或直肠黏膜上皮和腺体的恶性肿瘤,包括结肠癌和直肠癌。大肠癌的分类可以从多个角度进行,包括解剖部位、大体形态和组织学类型等。
1、按解剖部位分类
直肠癌:发生在齿状线至直肠乙状结肠交界处之间的癌,长度约15-18厘米。
左半结肠癌:包括左侧横结肠癌、降结肠癌和乙状结肠癌。
右半结肠癌:包括盲肠癌、升结肠癌和右侧横结肠癌。
2、按大体形态分类
大肠癌的大体分型根据肿瘤的形态和生长方式可分为以下几种:
早期大肠癌:
隆起型:肿瘤向肠腔内隆起,呈息肉状或乳头状。
表面型:肿瘤表面平坦或轻度隆起,可能伴有溃疡。
凹陷型:肿瘤呈溃疡状,局限于黏膜下层。
进展期大肠癌:
隆起型:肿瘤主体向肠腔突出,呈结节状或菜花状,表面可能有溃疡。
溃疡型:肿瘤表面形成深达肠壁肌层的溃疡,常向周围浸润。
浸润型:肿瘤沿肠壁生长,使肠壁增厚,肠腔变窄,表面常无明显隆起。
胶样型:肿瘤呈半透明胶冻状,外观和切面均类似胶冻。
3、按组织学类型分类
超过90%的结直肠癌是起源于结直肠粘膜上皮细胞的腺癌(adenocarcinoma)。 其他罕见类型的结直肠癌包括神经内分泌细胞癌(neuroendocrine)、鳞状细胞癌(squamous cell)、腺鳞状细胞癌(adenosquamous)、梭形细胞癌(spindle cell)和未分化癌。 常规腺癌以腺状结构为特征,这是肿瘤组织学分级的基础。在高分化腺癌>中,95%的肿瘤是腺形成的。 中分化腺癌显示50-95%的腺体形成。低分化腺癌多为实性,腺体形成率小于50%。 在实践中,大多数结直肠腺癌(约70%)被诊断为中分化(图2)。高分化癌和低分化癌分别占10%和20% [4]。下面将主要介绍几种腺癌的类型。

图2.中等分化腺癌例,在间质间质中可见复杂的腺体结构(放大原图×200) [4]。
3.1黏(粘)液腺癌(Mucinous adenocarcinoma)
这种特殊类型的结直肠癌的定义是肿瘤体积的50%由细胞外粘蛋白组成。 具有明显黏液成分(10% ~ 50%)的肿瘤通常被称为具有黏液特征或黏液腺癌。 黏液腺癌典型表现为大的腺状结构和细胞外黏液池(图3)。 可以看到数目不定的单个肿瘤细胞,包括印戒细胞(signet ring cells)。 在不同的研究中,粘液腺癌与常规腺癌的预后存在争议。 相比之下,微卫星稳定(MSS)的黏液腺癌表现出更强的侵袭性,特别是在晚期发现时。

图3.粘液腺癌显示丰富的细胞外黏液(原图×200) [4]。
3.2印戒细胞腺癌(Signet ring cell adenocarcinoma)
与胃相比,印戒细胞腺癌在结直肠中很少见,占所有结直肠癌的1%以下。 与黏液性癌相似,印戒细胞癌的定义是50%的肿瘤细胞表现出印戒细胞特征,其特征是胞浆内黏蛋白液泡突出,将细胞核推向外周(图4)。 印戒细胞可呈浸润性生长或存在于细胞外黏液池中。根据定义,印戒细胞癌是低分化的(高级别),其预后比传统腺癌更差 [4]。

图4.印戒细胞癌(放大原图×400) [4]。
3.3髓样癌(Medullary carcinoma)
髓样癌极为罕见,每10000例结直肠癌确诊病例中约有5-8例。这种肿瘤的特征是上皮样肿瘤细胞片,具有大的泡状核,突出的核仁和丰富的细胞质。它通常在切除标本上有一个推动边界(图5),并且典型地与显著的肿瘤浸润淋巴细胞相关(图6)。髓样癌是一种独特的组织学亚型,尽管其组织学为低分化或未分化,但预后良好 [4]。

图5.髓样癌在肿瘤边缘呈推入性边界(原图×40)[4]。
图6.髓样癌表现为组织学低分化和肿瘤浸润淋巴细胞(原图×400)[4]。
4、病理分期
结直肠癌的病理分期主要依据肿瘤浸润深度、淋巴结转移情况及远处转移情况,采用国际通用的TNM分期系统:
Ⅰ期:肿瘤局限于黏膜下层或肌层,无淋巴结转移。
Ⅱ期:肿瘤穿透肠壁,可能侵及邻近器官,但无淋巴结转移。
Ⅲ期:肿瘤浸润任何深度,伴有区域淋巴结转移,但无远处转移。
Ⅳ期:存在远处转移(如肝、肺、骨等)。
大肠癌的症状因肿瘤的部位、大小及发展阶段而异,早期症状通常较为隐匿,随着病情进展,症状会逐渐明显。
排便习惯改变:包括便秘、腹泻或便秘与腹泻交替出现,排便次数增多或排便不尽感。大便形状变细、变扁,甚至出现肠梗阻表现。
大便性状改变:出现血便、黏液便或脓血便,血液可能呈鲜红色或暗红色。
腹痛或腹部不适:持续性腹痛、腹部隐痛或钝痛,多位于中下腹部。部分患者可能伴有腹胀、消化不良。
腹部肿块:随着肿瘤生长,可能在腹部触及质地较硬的肿块,尤其多见于右侧结肠。
全身症状:体重下降、贫血、乏力、低热等,这些症状提示病情可能已进入晚期。
其他症状:直肠癌患者可能出现里急后重、肛门坠胀感。右半结肠癌患者可能因慢性失血导致贫血。
大肠癌的并发症多见于中晚期患者,严重影响患者的生活质量和预后。
肠梗阻:肿瘤堵塞肠腔导致肠梗阻,表现为腹痛、腹胀、呕吐、停止排气排便。
肠穿孔:肿瘤侵犯肠壁全层或肠道内压力过高导致肠穿孔,引起腹膜炎。
出血:肿瘤破溃引起肠道出血,表现为血便或黑便。
感染:肿瘤阻塞肠道导致细菌滋生,可能引起发热、败血症。
营养不良:瘤消耗大量能量,导致患者体重下降、乏力。
远处转移:常见转移部位包括肝脏、肺部,引起相应器官功能障碍。
术后并发症:包括切口感染、吻合口瘘、术后出血、肠梗阻、腹腔脓肿等。
结直肠癌在临床上诊断方法主要有直肠指诊、内镜检查、活检、影像学检查、血清学肿瘤标志物检查等。中华人民共和国国家卫生健康委员会在2024年版《结直肠癌筛查与早诊早治方案》中提出:推荐结肠镜检查作为一线筛查方法;不耐受或不依从一线筛查方法者,可选择免疫法或化学法的大便潜血检测、乙状结肠镜、结肠CT成像、多靶点粪便DNA检测等替代方法 [5]。
内镜筛查,尤其是结肠镜检查,被证实为结直肠癌预防和早期发现的有效手段 [6,7]。内窥镜的发展经历了早期硬管式内窥镜、半可屈式内窥镜、纤维内窥镜、电子内窥镜和胶囊内镜5个阶段。硬管式内窥镜,其设计简单但应用范围有限,主要用于直肠及部分结肠的检查。为了提升操作的灵活性并减轻患者的不适感,发展了半可屈式内窥镜。纤维内窥镜利用光纤传输图像,提高了图像清晰度,使医生能够更精确地识别肠道内的微小病变。
电子内窥镜提升了内窥镜的图像质量和操作便捷性。电子内窥镜在CRC早期诊断中的应用,已证明了其显著的临床价值。CRC 筛查中内镜筛查技术主要包括光学结肠镜和柔性乙状结肠镜检查,前者通过内镜直接观察结直肠的内部情况,可发现早期的肿瘤或息肉,并进行切除或活检,其优点是准确性高,可直接取材进行病理分析,缺点是侵入性大,肠道准备较为复杂,并且检查过程不适感强。柔性乙状结肠镜主要检查下段结肠,适用于初筛,其优点是操作简便、不适感较少,但可能遗漏上段结肠的病变。
结肠胶囊内镜虽有非侵入性和高舒适度的优点,但因胶囊内镜在检测肠道息肉的准确性较低,无法进行切除或活检,有卡在肠道的风险,且成本相对较高,限制了其在 CRC 筛查中的应用 [6及其参考文献]。
除了上述提到的几种常见的内镜检测方法外,还有CT 虚拟结肠镜,磁共振结肠镜,超声内镜等方法用于结直肠癌早期诊断和结直肠癌术前分期诊断 [7]。
CT 虚拟结肠镜又称 CT 结肠成像技术,是由 Vining 等于 1994 年首次提出的虚拟现实影像技术,主要原理是通过 CT 薄层扫描图像,分割并重建受检查者的结肠三维结构,便于医师通过观察结肠腔内的结构发现可疑病灶。CT 虚拟结肠镜,检查时间短,受检查者的耐受性较高,但操作前同样需要进行充分的肠道准备,并存在 X 线辐射的风险。急腹症、炎性肠病、内镜切除术后等为 CT 虚拟结肠镜的禁忌证 [7及其参考文献]。
磁共振结肠镜相对于 CT 虚拟结肠镜技术不存在辐射暴露等问题,与传统光学结肠镜相比,在诊断直径 <5 mm 的结直肠病变时,具有较高的敏感性和特异性。通常情况下,实施磁共振结肠镜同样需要进行肠道准备 [7及其参考文献]。
超声内镜兼具胃肠道超声检查和内镜检查的功能,能够对肠腔内的病变、肠壁结构、肠管周围结构、肿瘤组织浸润情况、癌细胞的淋巴结转移情况进行直接观察,并对结直肠癌术前分期做出诊断。超声内镜的主要诊断原理是根据淋巴结的回声、形态和大小来诊断转移淋巴结,因此在疾病诊断的客观性和统一性方面优势有限,容易受到炎性淋巴结的干扰,影响其对淋巴结转移分期情况诊断的准确率。为了准确地判断癌细胞的转移情况,可进行超声内镜引导下的细针穿刺。此外,三维超声内镜可提高成像分辨率,清楚地显示肠管解剖结构,提高对原发肿瘤分期和淋巴结转移分期诊断的准确率 [7]。
CT(Computed Tomography),即计算机断层扫描,是一种医学影像技术。它使用X射线束对人体进行层析扫描,并借助计算机处理产生身体内部结构的详细图像。CT 对不同组织的分辨是基于相邻组织密度的差异,由于结直肠壁各层密度差异较小,常规 CT技术较难分辨,在原发肿瘤Ⅰ期、Ⅱ期结直肠癌的判断中效果较差,而且肿瘤和机体高水平的炎症影响CT对结直肠癌原发肿瘤分期判断的准确性 [7]。
特殊成像技术能够在一定程度上解决 CT 对结直肠癌分期判断准确率较低的问题。多层螺旋 CT 具有薄层扫描、速度快、分辨率高的优势,扫描后可通过多平面重建、透明显示等技术进行后期处理,清楚地显示结直肠的病灶情况、淋巴结转移等情况,提高了结直肠癌术前分期判断的准确率。
核磁共振成像 (Nuclear Magnetic Resonance Imaging,NMRI),也称磁共振成像 (Magnetic Resonance Imaging,MRI),是利用核磁共振 (Nuclear Magnetic Resonance,NMR)原理,依据所释放的能量在物质内部不同结构环境中不同的衰减,通过外加梯度磁场检测所发射出的电磁波,即可得知构成这一物体原子核的位置和种类,据此可以绘制成物体内部的结构图像。
根据美国癌症联合会对结直肠肿瘤的分期标准,原位肿瘤的定位、大小、边缘,以及直肠系膜筋膜的浸润程度、肠外和血管的累及与否对治疗方案的选择至关重要。磁共振成像作为早期结直肠癌首选的分期工具,在肿瘤定位、决定切除范围及判断肿瘤与腹膜反折的关系方面均具有较高的准确性。磁共振成像具有分辨率高、无电离辐射、安全性高、准确率高的特点,能够清楚地显示癌细胞的浸润情况及其与周围组织结构的关系,是目前应用于结直肠癌诊断的重要影像学方法。磁共振成像对结直肠癌患者术前原发肿瘤分期判断的准确率明显高于CT。目前,随着磁共振成像磁场强度、梯度场强的提高及各种线圈的应用,磁共振成像在结直肠癌早期病变诊断中的优势更加明显,也解决了对结直肠癌原发肿瘤Ⅰ期与Ⅱ期判断准确率偏低的问题。
PET (Positron Emission Tomography)-CT又称正电子发射计算机断层显像技术。PET-CT将PET与CT融为一体,由PET提供病灶详尽的功能与代谢等分子信息,而CT提供病灶的精确解剖定位,一次显像可获得全身各方位的断层图像,达到早期发现病灶和诊断疾病的目的。
PET-CT成像的出现,是影像检查技术新的突破。CT弥补了PET在定位上缺陷。结直肠癌PET-CT显像最常用的显像剂2-氟-2-脱氧-D-葡萄糖 (18F-FDG),它能积聚于具有高代谢肿瘤组织,是常用于肿瘤病灶发现、分期以及监测的代谢性评估类放射性药物。PET-CT多模成像不仅融合了功能代谢现象个解剖形态,能在肿瘤早期(未发生形态变化)检测病灶,而且是全身显像,不易遗漏远处病灶。因而18F-FDG PET-CT对结直肠癌的诊断、分期、疗效评价及预后预测等提供可靠根据。一般情况的结直肠癌原发灶对18F-FDG是较高的放射性浓聚。18F-FDG PET-CT对结直肠癌病人局部淋巴结转移的诊断的准确性及特异性都尤为突出,尤其在小直径淋巴结的定性方面 [8及其参考文献]。
随着 PET-CT在临床的广泛应用以及人类医疗需求的提高,其局限性也逐渐显露,例如,CT 辐射剂量高,软组织分辨力低等。PET-MRI双模成像通过使用18F-FDG显像剂一次性扫描同步获得全身PET及MRI影像,从而为临床诊疗提供疾病的形态和功能代谢的双重特性。多模态PET-MRI与单模的PET或MRI比较成像的优点主要体现在:①PET的分子功能成像和MRI的解剖成像实现病灶的定性与定位;②MRI多参数、多序列成像多功能呈像与PET图像互相检验病灶;③MRI图像对PET图像的衰减和运动校正具有重要作用;④PET绝对定量信息对新的MRI成像序列和造影剂有验证作用。
目前PET-MRI已广泛用于结直肠癌研究。PET-MRI能清晰显示结直肠正常解剖结构及肿瘤大小、部位、浸润程度及邻近器官受累情况等;再者,DWI序列的使用可能进一步增加了对病灶浸润程度的诊断准确率。
粪便免疫化学检测 (FIT),也称为免疫化学粪便潜血试验 (iFOBT)是一种粪便检查,也可以检测粪便中的隐血。它也被称为血培养试验。
检测粪便中的血液很重要,因为它可能是癌前病变的征兆。较大的息肉或癌症表面的血管通常很脆弱,可能因排便而受损。受损的血管通常会向粪便中释放少量血液,这些血液通常肉眼看不见,这就是这些测试很有帮助的原因。
如果 FIT 检测呈阳性,将需要通过结肠镜检查找出便血的原因。虽然癌症和息肉会导致便血,但也有其他原因。溃疡、痔疮、憩室病(结肠壁薄弱处形成的小囊)或炎症性肠病(结肠炎)也可能导致便血。此外,与其他一些筛查测试(包括结肠镜检查)不同,这项测试建议每年重复 [9]。
粪便DNA检测是一种检测结直肠脱落细胞的基因突变和(或)甲基化的非侵入性检查方法,有单靶点和多靶点方案,也可与FIT联合检测(亦称为粪便FIT-DNA检测)。与单靶点检测相比,多靶点粪便DNA检测(mt-sDNA)对CRC及癌前病变的灵敏度更稳定,因此成为近年来的研究热点之一。
目前已经用于检测的基因如下:NDRG4和BMP3基因甲基化,KRAS基因突变,SDC2和SFRP2基因甲基化,SDC2和TFPI2基因的启动子甲基化,SDC2、ADHFE1和PPP2R5C基因甲基化联合检测。基于上述不同基因检测的试剂盒效果也有所不同,其中FIT-DNA试剂盒常卫清在2020年被我国国家药品监督管理局(NMPA)批准用于对结肠镜依从性差的CRC高风险人群的筛查。2023年,华常康被NMPA批准上市,但其诊断与筛查性能还需更多研究进一步评估 [10]。
在世界范围内,患结直肠癌的概率约为4%-5%。目前认为结肠癌是环境、饮食习惯、遗传等多种因素协同作用的结果。
结直肠癌的主要危险因素是年龄:超过50岁,发生结直肠癌的风险显著增加,而50岁以下的结直肠癌发病很少(除遗传性癌症外)。除了年龄,还有其他无法改变的固有风险因素。结直肠癌或炎症性肠病(IBD)的个人病史-溃疡性结肠炎患者的风险增加3.7%,而患有克罗恩病的人患结直肠癌的风险增加2.5%也是结直肠癌发展的重要风险。在IBD中发现的慢性炎症通常会产生异常的细胞生长,称为不典型增生。虽然发育不良的细胞还不是恶性的,但它们更有可能变成间变性并发展成肿瘤。另一个可以包括在这个群体中的危险因素是亲属中存在阳性的CRC家族史,特别是那些在诊断时年龄在50岁以下的亲属。家族史导致的风险增加可能来自遗传突变或环境因素 [11]。
与生活方式有关的其他一些风险因素可以通过在饮食和体育活动习惯方面适度改变生活方式来减少。例如,人们认为久坐不动的生活方式会增加患结直肠癌的风险,尽管结直肠癌和不运动之间的关系还没有完全确定。然而,已经证明适度的体育活动可以提高代谢率和肠道蠕动,从长远来看,可以提高代谢效率并降低血压。
久坐不动的生活方式也与肥胖有关,肥胖是结直肠癌的另一个重要风险因素。值得注意的是,这种增加的风险与食物摄入和内脏脂肪组织(VAT)水平的增加有关,VAT是全身脂肪中激素活性成分,可以通过促炎细胞因子的分泌促进结直肠癌的发展,促炎细胞因子导致结肠和直肠的炎症状况,胰岛素抵抗和代谢酶的调节,如脂联素或凝集素[12]。在这种情况下,饮食与结直肠癌的风险密切相关,因此不健康的营养习惯会使患结直肠癌的几率增加高达70%。
此外,吸烟和饮酒也被证明会增加结直肠癌的风险。在饮酒的情况下,乙醛(乙醇的主要代谢物)已被描述为致癌物质,通过增加人群中发生结肠直肠癌的风险,这取决于酒精代谢酶的多态性[13]。然而,饮酒与结直肠癌之间的关系尚未完全阐明。吸烟可使患结直肠癌的几率增加10.8%,因为吸烟中尼古丁等致癌物含量高,其代谢物很容易到达肠道并产生息肉[14]。尽管吸烟会增加结直肠癌的风险,但只有长期吸烟者才发现了显著的关系,无论他们是否已经戒烟。
肠道内的微生物群落及其代谢产物与结直肠癌的发生发展密切相关,如具核梭杆菌等致病菌在肠黏膜的聚集可能参与结直大肠癌的发生过程。
与其他类型的癌症一样,特定基因的突变可能导致结直肠癌的发生。这些突变可能出现在致癌基因、肿瘤抑制基因和与DNA修复机制相关的基因中。根据突变的来源,结直肠癌可分为散发性、遗传性和家族性。
点突变出现在生命过程中,与遗传综合征无关,只影响单个细胞及其后代。源自点突变的癌症被称为散发性癌症,占所有结直肠癌的70%。散发性癌症的分子发病机制是异质性的,因为突变可以靶向不同的基因[15]。然而,大约70%的CRC病例遵循特定的突变序列,然后转化为特定的形态序列,从腺瘤的形成开始,以癌状态结束。第一个突变发生在大肠腺瘤性息肉病(APC)中,这是一种肿瘤抑制基因,引发非恶性腺瘤的形成,也称为息肉。大约15%的腺瘤预计在10年内发展为癌。APC突变之后是KRAS、TP53和DCC的突变[15]。
遗传性癌症仅占所有结直肠癌病例的5%。这些癌症是由影响突变基因的一个等位基因的遗传突变引起的,这意味着另一个等位基因的点突变将触发肿瘤细胞的出现,随后是癌症。为了对遗传性癌症进行更准确的分类,已经建立了两组,即息肉病和非息肉病形式。息肉变异型主要涉及家族性腺瘤性息肉病(FAP),其特征是在结肠中形成多个潜在的恶性息肉。相反,遗传性非息肉病性结直肠癌(HNPCC)与DNA修复机制的突变有关。HNPCC的主要病因是Lynch综合征,Lynch综合征是由编码DNA修复蛋白(如MSH2、MLH1、MLH6、PMS1和PMS2)的一个等位基因的遗传突变引起的。Lynch综合征占所有结直肠癌病例的2%-3%,是HNPCC组中最常见的综合征[16,17]。家族性结直肠癌约占所有病例的25%,也是由遗传突变引起的,尽管它们本身不被归类为遗传性癌症,因为它们不能包括在任何遗传性癌症变体中。
基因组不稳定性是结直肠癌的一个重要特征 [18]。导致这种情况的致病机制可以包括三种不同的途径,即染色体不稳定性(CIN, chromosomal instability)、微卫星不稳定性(MSI, microsatellite instability)和CpG岛甲基化表型(CIMP, CpG island methylator phenotype)。
CIN途径也被认为是经典途径,因为它代表了高达80%-85%的CRC病例的病因,其特征是染色体数量不平衡,从而导致非整倍性肿瘤和杂合性丧失(LOH)。CIN的机制包括染色体分离、端粒功能障碍和DNA损伤反应的改变,这些改变会影响参与维持正确细胞功能的关键基因,如APC、KRAS、PI3K和TP53等。APC突变导致β-catenin易位到细胞核,并驱动与肿瘤发生和侵袭有关的基因的转录,而KRAS和PI3K突变导致MAP激酶的持续激活,从而增加细胞增殖。最后,编码p53(主要细胞周期检查点)的TP53的功能缺失突变导致不受控制地进入细胞周期 [19]。

图7.结直肠癌发生的多步骤遗传模型。结直肠癌发生的第一步是异常隐窝灶(ACF)的形成。由于APC基因的突变,Wnt信号通路的激活可能在这一阶段发生。发展为较大的腺瘤和早期癌需要激活原癌基因KRAS突变、TP53突变和18q染色体杂合性缺失。在一小部分结直肠癌中,PIK3CA的突变激活发生在腺瘤-癌序列的晚期。在良性腺瘤中观察到染色体不稳定性,并随着肿瘤进展而增加。本图改自[19]。
微卫星不稳定途径是由DNA修复机制缺失引起的超可变表型引起的。在具有微卫星不稳定性的肿瘤中,修复短DNA链或串联重复序列(2至5个碱基对重复序列)的能力下降;因此,突变倾向于在这些区域积累。这些突变既可以影响非编码区,也可以影响编码微卫星,当微卫星中编码的致癌基因或肿瘤抑制基因的读码框发生改变时,肿瘤就会发生。错配修复基因(MMR)的表达缺失可由自发事件(启动子超甲基化)或生发突变(如Lynch综合征中的突变)引起。这些肿瘤主要是二倍体,含有较少的LOH。在微卫星不稳定肿瘤中发生突变的基因包括MLH1、MSH2、MSH6、PMS1和PMS2[20]。一般来说,MSI肿瘤比散发性肿瘤预后好。

图8.DNA MMR系统通过一系列步骤发挥作用。(A) MSH2-MSH6 (MutSα)识别单个碱基对错配,其中DNA聚合酶将错误的碱基(G)与模板上的T匹配(左图所示),并在DNA周围产生滑动夹。这一步骤需要将三磷酸腺苷(ATP)交换为二磷酸腺苷(ADP)(由MSH2,而不是MSH6或MSH3)。该复合物从错配位点扩散,然后由MLH1-PMS2 (mutl - α)复合物结合(右)。这个“媒人”复合体沿着新的DNA链移动,直到遇到DNA聚合酶复合体。(B) DNA MMR蛋白滑动钳与核酸外切酶-1、增殖细胞核抗原(PCNA)和DNA聚合酶相互作用。这个复合体将子链切除到不匹配的位置(如图所示)。最终,复合体从DNA上脱落,重新合成发生,纠正错误。(C) DNA MMR主题的变异。虽然MSH2-MSH6识别单对错配和小idl,但MSH2-MSH3 (MutSβ)通过识别更大的idl来补充这一点(如图所示)。右侧显示了与不同的MutL二聚体可能的相互作用,因为MLH1可以与PMS2、PMS1或MLH3二聚。与MSH2-MSH3的首选相互作用是MLH1-MLH3 (MutLγ),但其他MutL异源二聚体在该反应中的确切作用尚不完全清楚 [20]。
表观遗传不稳定性是导致CpG岛甲基化表型的原因,是CRC的另一个共同特征。CIMP肿瘤的主要特征是癌基因启动子的高甲基化,导致基因沉默和蛋白质表达缺失。在结直肠癌中,遗传学和表观遗传学并不是唯一的,它们在结直肠癌的发展中相互合作,通常发现的甲基化事件多于点突变 [21]。
新的基因组技术允许识别与结直肠癌有关的大量基因组畸变。因此,尽管突变是主要的基因组改变,但在 CRC 中也经常发现一些染色体变化和易位。所有这些畸变都会影响细胞内的重要通路(WNT、MAPK/PI3K、TGF-β)和功能(TP53 和细胞周期调控)(图9)。

图9.参与结直肠癌变的分子途径。影响 WNT(橙色)、MAPK/PI3K(绿色)、SMAD/TGF-β(蓝色)或 DNA 修复(紫色)途径的蛋白质的突变可能会增强细胞增殖和存活,从而诱导肿瘤过度生长并启动致癌作用。箭头线表示蛋白质激活,而条形线表示蛋白质抑制 [18]。
此外,肿瘤的整体基因组背景在 CRC 中具有临床相关性。尽管有人认为过量的基因组不稳定性可以激活各种细胞死亡机制,但其潜在机制仍不清楚。因此,体细胞 DNA 畸变的分子表征是改善个体患者预后预测和治疗选择的有用策略,构成了现代和个性化医学的最重要基础之一。
目前,CRC患者的一线治疗选择涉及基于肿瘤相关特征(如转移灶数量和定位、肿瘤进展、有无生化标志物等)和患者相关因素(如合并症、预后等)的多模式方法。在实践中,所有这些方面都被用于将CRC患者分为四种不同的风险组之一,这些风险组将用于指导治疗策略。
第0组:癌细胞未发生转移或为可切除的肝或肺转移且无不良预后体征(例如,辅助治疗期间复发)的患者。在这种情况下,推荐的治疗方式为手术切除转移灶。化疗对于这一组的患者并没有优势[18]。
第1组:具有可切除转移性病灶的患者。这些患者最初接受诱导化疗,以减少转移灶的数量和大小,并使后续手术切除成为可能。这些病例的推荐化疗包括细胞毒性双联或三联,在KRAS野生型肿瘤中可与anti-VEGF或 anti-EGFR 策略联合使用[22,23]。
第2组:弥散性不可切除疾病患者。为这组患者选择的治疗将是姑息性的,而不是治愈性的,主要目的是减轻症状,减少疾病的侵袭性和扩展。因此,选择的一线治疗应该在短时间内诱导转移性消退。为此,首选方案通常包括细胞毒性双重药物与靶向药物(抗vegf或抗egfr策略)联合使用。在对治疗有反应的少转移患者中,可以考虑采用额外的消融方法来增加无进展间期。如果不能使用消融方法,应研究降低初始联合剂量作为维持治疗。在某些情况下,可以考虑完全停止治疗 [22,23]。
第3组:不可切除且缺乏强化或序贯治疗的患者:对于没有症状且恶化风险低的患者,治疗的目的将是防止肿瘤进展并延长无治疗寿命。最常用的策略包括将氟嘧啶作为细胞毒剂与生物靶向剂联合或不联合使用 [22,23]。
如上所述,大多数转移性结直肠癌患者采用细胞毒性和靶向生物制剂联合治疗。以缓解为目的的一线化疗包括氟嘧啶(例如,5-氟尿嘧啶(5-FU)或卡培他滨)单独或联合亚叶酸钙(LV)以及其他细胞毒性药物,如奥沙利铂(5-FU/LV/奥沙利铂(FOLFOX)和卡培他滨/LV/奥沙利铂(CAPOX))或伊立替康(5-FU/LV/伊立替康(FOLFIRI))。亚叶酸钙的使用降低了治疗的毒性,而添加其他细胞毒性药物已被证明可以提高缓解率和无进展生存期,尽管治疗的毒性作用也会加剧[23, 24]。
二线化疗将提供给器官功能良好的患者,并应根据难治性方案进行选择。对伊立替康难治性患者的二线治疗将包括含奥沙利铂的联合治疗,如FOLFOX或CAPOX,而对FOLFOX或CAPOX难治性患者将接受伊立替康单药治疗或FOLFIRI[24]。
化疗的最佳持续时间取决于每个病例,有三种不同的选择:固定治疗3-6个月,诱导治疗后再进行维持治疗,或治疗至毒性或进展[23]。
除化疗外,针对血管内皮生长因子(VEGF)和表皮生长受体(EGFR)的单克隆抗体或蛋白联合传统化疗已被证明可改善mCRC的预后[23]。最常用的抗vegf策略是单克隆抗体贝伐珠单抗(针对循环VEGF-A)和重组融合蛋白Aflibercept(阻断VEGF-A、VEGF-B和胎盘生长因子)。当与细胞毒性药物联合使用时,它们代表了几乎所有CRC患者的一线治疗。相比之下,抗EGFR治疗只能在没有KRAS突变的情况下使用,要么作为单一药物,要么与细胞毒性分子联合使用。最重要的抗EGFR药物包括单克隆抗体,如西妥昔单抗或帕尼单抗[23]。
除了传统的化学疗法外,人们正在研究替代疗法,目的是提高治疗效果,减少副作用以及发生继发性肿瘤的风险。目前正在进行的最重要的研究方向是琼脂糖肿瘤巨珠(agarose tumour macrobeads)、抗炎药(anti-inflammatory drugs)和金基药物(gold-based drugs)等的使用。
1、琼脂糖巨珠法
器官和肿瘤的生长遵循Gompertzian曲线,即趋近于渐近线或随增大而减小的递减指数曲线。这一证据表明肿瘤和器官一样,容易受到正向和负向生长调控的影响。这说明肿瘤肿块存在的生物信号会减少或阻止肿瘤生长,即使该肿块不存在[25]。这一假设构成了使用亲水性琼脂糖巨珠培养细胞用于阻止结直肠癌生长的基础。
琼脂糖巨珠由两个同心的琼脂糖层组成,形成了一个可以容纳癌细胞的内部空间[26]。各种肿瘤细胞系在琼脂糖大珠包封后都有形成细胞群落的能力,目前的治疗方案使用RENCA细胞(一种小鼠肾皮质腺癌细胞系)。随着细胞群落的扩大,它们的生长速度会减慢,直到它们在封装后6到24个月左右达到稳定的大小。限制生长的琼脂糖环境诱导肿瘤抑制分子的产生,这些分子能够在体外和体内抑制非包被癌细胞的增殖[26]。目前RENCA巨珠抑制生长的机制尚不清楚。不同的实验结果表明,RENCA巨珠延长了S期周期时间,减少了有丝分裂数。
RENCA巨珠已在I/II期临床试验中用于晚期上皮源性癌症。总的来说,RENCA大珠对患者的耐受性良好。II/III期临床试验目前正在进行中,这种治疗的未来前景相当令人鼓舞。
2、抗炎药
慢性炎症是结直肠癌的共同特征,是由免疫细胞及其产物(细胞因子和趋化因子)、活性氧和活性氮(ROS和RNS)以及一些花生四烯酸衍生物引起的,主要通过环氧合酶(COX)和脂氧合酶(LOX)途径产生。这种炎症状态参与肿瘤生长、增殖、侵袭和抵抗[27]。
由于已知炎症在结直肠癌的发生和发展中起着重要作用,因此许多抗炎药物在结直肠癌的预防和治疗中变得重要。大多数使用的抗炎药是非甾体抗炎药(NSAIDs),其抑制COX酶,从而阻断花生四烯酸衍生物的合成。例如,阿司匹林在预防结直肠癌方面显示出良好的效果,可将风险降低高达50%。此外,舒林达克联合阿托伐他汀甚至被证明可以抑制肿瘤生长 [28]。
尽管非甾体抗炎药具有抗炎特性,但也存在胃肠道溃疡或肾脏损害等副作用,因此多用于预防高危患者的结直肠癌,而非用于治疗。为了避免这些副作用,一种特异性抑制环氧化酶2 (COXibs)的新型非甾体抗炎药被开发出来,用于预防和治疗CRC。虽然它们不影响胃肠道系统,但其中一些化合物,如2004年退出市场的罗非昔布(rofecoxib),可产生心血管毒性。这组COXib中最重要的药物是塞来昔布,它已被证明可以预防结直肠癌和减少腺瘤,即使是在晚期。此外,塞来昔布不会对胃肠道产生不良影响,也不会产生心血管问题。此外,正在研究新的配方,以进一步减少已知的副作用。这些新药的一个例子是塞来昔布微珠,它只针对结肠细胞。塞来昔布也与姜黄的产物姜黄素联合试验,获得协同抗癌效果 [29]。
3、金属基药物(Metal-Based Drugs)
把金属用于治疗可以追溯到古代。然而,无机化学在医学上最重要的成就之一是顺铂的发现。顺铂(cis-PtCl2(NH3)2)及其抗癌特性是在20世纪60年代偶然发现的。从那时起,为了治疗癌症,许多其他含金属化合物被开发出来。在这里,我们将讨论最有希望的候选药物,即铂和金,以及它们在结直肠癌化疗中的应用。
顺铂是在化疗中使用金属的先驱。它的成功源于它的作用机制:顺铂能够结合DNA,从而诱导细胞凋亡。一旦进入细胞,顺铂在主要沟鸟嘌呤的N7位置与DNA发生反应,这是最暴露和亲核的位置。尽管其具有活性,但由于其作用机制,使用顺铂会导致严重的副作用。最相关的副作用是肾损伤和听力损失。此外,已观察到肿瘤对顺铂治疗的耐药性增加。最广泛的耐药机制涉及顺铂-DNA加合物修复的增加。
为了保持顺铂的疗效而不受其缺点的影响,以奥沙利铂和卡铂为代表的许多类似物被开发出来。因此,奥沙利铂是大肠癌化疗中最常用的药物之一。奥沙利铂或反式-l-二氨基环己环草酸铂的重要性在于与顺铂没有交叉耐药,因此可以在肿瘤对该药产生耐药时使用。但更值得注意的是,奥沙利铂没有引起耳毒性和肾毒性。奥沙利铂通常与5-氟尿嘧啶/亚叶酸钙输注联合使用,称为FOLFOX方案。FOLFOX大大提高了缓解率:5-氟尿嘧啶治疗的缓解率为20%,而与奥沙利铂联合治疗的缓解率可提高至50% [30]。5-氟尿嘧啶联合奥沙利铂在转移性患者中也提供了更好的生存率 [30]。
在过去的几十年里,许多含有金(I)或金(III)的金属抗癌药物被设计出来。其中一种最具特征的含金抗癌药物被称为金嘌呤。[2,3,4,6- four -o-acetyl-1-thio-β-d-glycopyranosato (triethylphosphine) gold],是一种含膦和硫醇配体的金(I)化合物。金嘌呤的作用机制包括抑制硫氧还蛋白还原酶,导致活性氧增加,引起氧化应激,最终引发细胞凋亡 [31]。因此,即使在顺铂耐药的癌细胞中,金嘌呤也能诱导细胞凋亡 [32]。
抑制硫氧还蛋白还原酶并不是含金药物抗结直肠癌的唯一机制。这种亲和性可扩展到所有含金药物。特别是,金(I)衍生物破坏氧化还原平衡,增加细胞内ROS水平并改变线粒体膜电位,从而诱导凋亡级联的激活并导致受控细胞死亡,而不是影响核酸 [33]。
本病属于肠覃、脏毒、肠癖、癥痕、锁肛痔、便血等范畴。中医认为本病的主要病因病机为饮食不节、 肥甘厚味、过食炙、或喜怒不测、或房劳太过、阴阳失调、脏腑虚弱,湿热蕴毒,壅塞肠中,气血瘀阻,结为癌瘤。
【辨证用方】
大肠癌的辨证,当辨明热、寒、虚、实证。以腹胀疼痛大便脓血、里急后重、肛门灼热为主症者, 多为热证(湿热)实证;以腹部隐痛、便血黯淡、肛门坠胀为主症者,多为虚证、寒证。 证属实热者,治以清热利湿、化瘀解毒为主,证属虚寒者,治以温中健脾、软坚散结为主。
1.湿热蕴结证
【主症】腹部阵痛,大便脓血,里急后重,肛门灼热,或有发热,舌质红,苔黄腻,脉滑数。
【治法】清热化湿,宽肠散结。
【主方】加减白头翁汤 (《中华肿瘤治疗大成》)
【组成与用法】白头翁30g,黄柏12g,黄连5g,秦皮15g,广木香15g,厚朴15g,苍术15g, 赤芍12g,槐花20g,甘草5g,败酱草30g,生薏苡仁30g,白花蛇舌草30g。水煎服。
【功能主治】清热燥湿,凉血解毒。主治大肠癌。
【加减应用】痛引两胁者,加柴胡、郁金;热结便秘者,加大黄;便血多者,加地榆炭、炒荆芥、三七粉(冲服)。
2.瘀毒内结证
【主症】烦热口渴,腹痛腹胀,大便脓血,血色紫黯,里急后重,舌质紫黯或有瘀点,脉滞涩或细数。
【治法】清热解毒,化瘀软坚。
【主方】加减仙方活命饮(《中华肿瘤治疗大成》)
【组成与用法】金银花20g,炮山甲(先煎)10g,天花粉20g,炒皂角刺12g,当归10g,赤芍10g,乳香5g, 没药5g,广木香15g,厚朴15g,败酱草30g,生薏苡仁30g,蚤休30g,甘草5g。水煎服。
【功能主治】清热解毒,活血祛瘀。主治大肠癌。
【加减应用】腹硬满痛甚者,加枳实、槟榔;排便困难者加大黄、桃仁;发热偏甚者,加丹皮、生地。
3.脾胃虚寒证
【主症】腹胀隐痛、大便带血,血色黯淡,久得不止,而色委黄,四肢不温,舌质淡,苔薄自,脉沉细无力。
【治法】温阳健脾,止血散结。
【主方】加减黄土汤(《中华肿瘤治疗大成》)
【组成与用法】伏龙肝(先煎取汁)30g,熟地10g,白术10g,制附片(先煎)10g,黄芩10g, 阿胶(烊化)12g,陈皮10g,甘草5g,蚤休20g,夏枯草30g。水煎服。
【功能主治】温阳健脾,养血止血。主治大肠癌。
【加减应用】里急后重者,加广木香、巴天; 便黯红量多者,加炒艾叶、地榆炭; 大便泻下无度者,加诃子、罂粟壳。
4.脾虚下陷证
【主症】腹部坠胀,气短懒言,食少乏力,大便稀溏,面色苍白。甚则脱肛,舌质淡胖,苔薄白,脉沉细无力。
【治法】益气健脾,升阳举陷。
【主方】加减补中益气汤(《中华肿瘤治疗大成》)
【组成与用法】炙黄芪20g,党参20g,白术12g,陈皮10g,炙升麻10g,炙柴胡10g, 当归10g,炙甘草5g,怀山药20g,积壳10g,桔梗10g,蚤休20g,自花蛇舌草20g,水煎服。
【功能主治】补中益气,升阳举陷。主治大肠癌。
【加减应用】大便带血、心悸失眠者,加酸枣仁、炒艾叶伏龙肝; 短气汗多者,加红参、麦冬、五味子。
5.气血双亏证
【主症】面色苍白,肌肤甲错,头昏眼花,心悸气短,体瘦腹满,腹胀硬满拒按,舌淡红,苔薄白,脉细弱。
【治法】益气补血,健脾养心。
【主方】加减归牌汤(《中华肿瘤治疗大成》)
【组成与用法】黄芪15g,党参15g,白术12g,茯苓12g,广木香15g,陈皮10g,当归10g, 龙眼肉10g,酸枣仁12g,甘草5g,枳实10g,蚤休20g,䗪虫10g。水煎服。
【功能主治】补益气血,健脾养心。主治大肠癌。
【加减应用】气虚甚者,加红参; 大便秘结者,加大黄桃仁; 便血不止者,加炮姜炭、伏龙肝; 腹胀甚者,加厚朴沉香粉。
大肠癌患者的生存期受肿瘤分期、病理类型、治疗方式及患者身体状况等多种因素影响,以下是不同情况下的大致生存期分析。
早期
Ⅰ 期:肿瘤局限于肠壁内,未发生淋巴结转移和远处转移。此时进行根治性手术切除后,患者的 5 年生存率较高,可达 90% 左右,许多患者可实现长期生存,甚至被认为临床治愈,生存期可能超过 10 年、20 年,甚至更长时间,具体与个体差异有关。
中期
Ⅱ 期:肿瘤侵犯至肠壁外,但无淋巴结转移。经过手术切除并结合术后辅助放化疗等综合治疗,5 年生存率约为 70%~80%,患者的中位生存期可能在 5 年至 10 年左右。
Ⅲ 期:肿瘤已经发生区域淋巴结转移,但尚未出现远处转移。采取手术联合放化疗等综合治疗后,5 年生存率约为 30%~60%,中位生存期一般在 3 年至 5 年左右。
晚期
Ⅳ 期:肿瘤出现远处转移,如肝、肺、骨等器官转移。此类患者预后相对较差,在不进行积极治疗的情况下,生存期可能仅为几个月至 1 年左右。但如果采取积极的综合治疗,包括化疗、靶向治疗、免疫治疗等,部分患者的生存期可延长至 2 年至 3 年左右,少数对治疗反应良好的患者可能生存 5 年以上。
按病理类型划分
高分化腺癌:癌细胞分化程度高,恶性程度相对较低,生长速度较慢,预后相对较好。在相同分期情况下,高分化腺癌患者的生存期可能比低分化腺癌患者长 10% - 20% 左右。
低分化腺癌和未分化癌:癌细胞分化程度低,恶性程度高,侵袭性和转移性强,容易早期出现复发和转移,预后较差。这类患者的 5 年生存率可能比高分化腺癌患者低 20% - 30% 左右,生存期明显缩短。
黏液腺癌:具有独特的生物学行为,预后一般介于高分化腺癌和低分化腺癌之间,5 年生存率通常比高分化腺癌略低,但比低分化腺癌稍高。
1、治疗方式对预后的影响
手术治疗:手术是大肠癌的主要治疗手段,早期手术切除可显著提高患者的生存率。
化疗和放疗:化疗和放疗常用于中晚期患者,可延长生存期并改善预后。
靶向治疗:靶向药物的应用显著改善了转移性大肠癌患者的预后,中位生存期从传统化疗的6个月延长至24-28个月。
免疫治疗:免疫治疗在微卫星高度不稳定(MSI-H)或错配修复缺陷(dMMR)的大肠癌患者中表现出显著疗效,可显著延长生存期。
2、基因特征对预后的影响
MSI-H/dMMR型大肠癌:这类患者对免疫治疗反应良好,预后较好。例如,帕博利珠单抗等免疫检查点抑制剂在MSI-H型患者中可显著延长无进展生存期(PFS)和总生存期(OS)。
MSS/pMMR型大肠癌:这类患者对单药免疫治疗反应较差,但联合治疗(如靶向药物+免疫治疗)显示出一定的疗效。
3、新辅助治疗的预后改善
新辅助免疫治疗:在局部进展期dMMR/MSI-H型大肠癌中,新辅助免疫治疗可显著提高病理完全缓解率(pCR),改善术后预后。
新辅助放化疗:对于局部晚期直肠癌,新辅助放化疗可缩小肿瘤,提高手术切除率和生存率。
大肠癌的预防主要分为一级预防和二级预防,具体措施如下:
【一级预防】
改变生活方式:控制脂肪摄入,增加膳食纤维的摄入,多吃全谷物、豆类、蔬菜和水果。
戒烟限酒:避免吸烟和过量饮酒,减少对肠道的刺激。
保持健康体重:通过规律运动和合理饮食控制体重,避免肥胖。
预防癌前病变:积极治疗肠道息肉、溃疡性结肠炎等癌前病变。
药物预防:非甾体类抗炎药(如阿司匹林)可降低大肠癌的发生风险,但需在医生指导下使用。
【二级预防】
定期筛查:高危人群(如有家族史、长期不健康饮食、曾患肠道息肉等)应定期进行肠镜检查、粪便隐血试验等。
早诊断早治疗:及时发现并处理肠道息肉,尤其是腺瘤性息肉。
关注早期症状:如便血、排便习惯改变、体重快速下降等,及时就医。
大肠癌的护理贯穿术前、术后及康复期,具体措施如下:
【术前护理】
营养支持:术前给予高热量、高蛋白、高维生素的易消化饮食,必要时静脉补充营养。
肠道准备:术前3天进少渣半流质饮食,术前1天禁食,口服泻剂和灌肠,直至排出澄清液。
心理支持:帮助患者缓解焦虑情绪,树立积极心态。
【术后护理】
早期活动:鼓励患者术后尽早下床活动,促进肠道蠕动,预防肠粘连。
饮食调整:术后从流质饮食逐步过渡到软食,避免刺激性食物。
伤口护理:保持伤口清洁干燥,定期更换敷料,观察伤口有无红肿、渗液。
造口护理:对于造口患者,需在医生指导下进行造口清洁和更换造口袋。
【康复期护理】
营养补充:提供高蛋白、高能量、易消化的食物,必要时给予营养补充剂。
心理支持:提供心理辅导,帮助患者应对术后生活变化,减轻焦虑和抑郁情绪。
定期复查:术后定期复查,监测病情变化,及时发现并处理复发或转移。
1、高蛋白摄入
2、补充充足的维生素和矿物质
3、适量的脂肪
4、选择易消化的食物
5、少食多餐
6、增加膳食纤维的摄入
1、避免高脂肪类食物
2、避免高糖类食物
3、避免海鲜类食物
4、避免辛辣刺激性食物
5、避免油炸、腌制食物
6、避免咖啡等兴奋性饮料
7、戒烟限酒
食疗方 1
【组成】南瓜55克,虾皮20克,大白菜适量,面粉适量,葱姜、蒜、油各适量。
【制作】面粉加水调成硬度适中的面粉糊;将南瓜、大白菜虾皮、葱、姜、蒜一起剁碎制成馅,入一勺面糊摊成饼状,加一匙面糊摊匀,馅上再摊一层面粉糊,人油锅炸熟即可。
【功效】 适用于饮食不振、浮肿、少尿的癌症病人。
备注:更多食疗方见肿瘤药膳专栏,或点击本页相关文章栏目相应文章链接阅读。